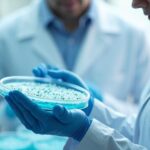
디자이너 미생물, 메틸수은 해독 열쇠 될까

APOE4가 뇌 면역세포에 미치는 영향…알츠하이머 진행 메커니즘 밝혀져
알츠하이머 위험 유전자 APOE4가 뇌 면역세포인 미세아교세포의 기능을 변화시켜 병리 악화를 유도한다는 연구 결과가 나왔습니다. 반대로, APOE2는 뇌 염증을 억제하고 보호 작용을 강화하는 것으로 나타났습니다.
APOE 유전자형에 따라 달라지는 알츠하이머 위험
APOE4는 알츠하이머 위험 증가에 관여
알츠하이머 발병과 밀접하게 연관된 APOE 유전자는 3가지 형태(APOE2, APOE3, APOE4)로 존재합니다. 이 중 APOE4 보유자는 알츠하이머 발병 위험이 현저히 높아지는 것으로 알려져 있습니다.
반대로, APOE2는 병에 대한 보호 효과를 가지는 희귀 유전자형으로 평가받고 있습니다.
뇌 면역세포 기능, APOE에 따라 달라진다
인간 유래 미세아교세포 이식 실험 진행
킹스칼리지 런던 소속 연구진은 APOE 유전자가 뇌 면역세포인 미세아교세포(microglia)에 어떤 영향을 미치는지 확인하기 위해 새로운 모델을 활용했습니다. 인간 줄기세포에서 유도한 미세아교세포를 APOE 유전자형별로 제작해 알츠하이머 유사 마우스 뇌에 이식했습니다.
그 결과, 각 APOE 유전자형에 따라 미세아교세포의 유전자 발현, 염증 반응, 이동성, 식세포 작용 등이 뚜렷하게 차이를 보였습니다.
APOE4, 뇌 염증 악화와 방어 기능 저하 유발
염증성 사이토카인 증가 및 식세포 작용 저하
APOE4를 가진 미세아교세포에서는 다음과 같은 변화가 관찰됐습니다.
- 염증성 사이토카인 생산 증가
- 세포 이동성 감소
- 유해 물질 제거 능력(식세포 작용) 저하
- 신경세포 보호 기능 약화
이러한 변화는 궁극적으로 알츠하이머 병리 악화를 가속화할 수 있음을 시사합니다.
APOE2, 신경 보호에 유리한 유전자형
비타민 D 수용체 활성이 높아 보호 효과 유추
반대로 APOE2 미세아교세포는 염증 반응이 억제되고, 세포 증식 및 이동 관련 유전자 활성이 증가했습니다. 더욱이, 비타민 D 수용체의 DNA 결합 활성도 높게 나타났습니다.
이는 비타민 D가 인지 기능 보호 및 알츠하이머 예방에 도움을 줄 수 있는 경로로 작용할 가능성을 열어주는 발견입니다.
비타민 D와 APOE의 상관성에도 주목
비타민 D가 알츠하이머 위험에 미치는 영향을 둘러싼 많은 연구에서, 비타민 D 결핍이 치매 위험 증가와 연관되어 있음이 지적돼 왔습니다. 이번 연구는 APOE2가 비타민 D 수용체 활동을 높일 수 있다는 점에서 두 요소 간 상호작용 가능성을 시사합니다.
유전자형이 뇌 면역 반응에 끼치는 결정적 영향
이번 연구는 유전자형이 뇌 내 면역세포의 반응성과 기능을 어떻게 변화시키는지를 상세히 규명했다는 데 큰 의의가 있습니다. 특히 APOE4 유전자가 질병 진행을 유도할 수 있는 메커니즘을 구체적으로 밝힌 점에서 향후 맞춤형 치료 개발의 실마리를 제공할 수 있습니다.
핵심 요약
- APOE4는 미세아교세포 기능을 악화시켜 알츠하이머 병리 진행을 촉진합니다.
- APOE2는 면역 조절 및 신경 보호 기능을 강화하며, 비타민 D 수용체 활성이 높습니다.
- 유전자형에 따라 뇌 내 면역 반응이 다르게 작동하며, 비타민 D와의 상호작용 가능성도 주목됩니다.
출처 : 원문 보러가기